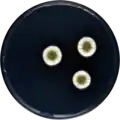
Aspergillus jensenii growing on CYA plate

Aspergillus jensenii
| Aspergillus jensenii | |
|---|---|
| Scientific classification | |
| Kingdom: | Fungi |
| Division: | Ascomycota |
| Class: | Eurotiomycetes |
| Order: | Eurotiales |
| Family: | Aspergillaceae |
| Genus: | Aspergillus |
| Species: | A. jensenii
|
| Binomial name | |
| Aspergillus jensenii Jurjević, S.W. Peterson & B.W. Horn (2012)[1]
| |
Aspergillus jensenii is a species of fungus in the genus Aspergillus. It is from the Versicolores section.[1][2] The species was first described in 2012.[1]
Growth and morphology
A. jensenii has been cultivated on both Czapek yeast extract agar (CYA) plates and Malt Extract Agar Oxoid® (MEAOX) plates. The growth morphology of the colonies can be seen in the pictures below.
-
Aspergillus jensenii growing on CYA plate
Aspergillus jensenii growing on CYA plate -
 Aspergillus jensenii growing on MEAOX plate
Aspergillus jensenii growing on MEAOX plate
References
- ^ a b c Jurjevic, Zeljko; Peterson, Stephen W.; Horn, Bruce W. (2012). "Aspergillus section Versicolores: nine new species and multilocus dNA sequence based phylogeny". IMA Fungus. 3 (1): 59–795. doi:10.5598/imafungus.2012.03.01.07. ISSN 2210-6340. PMC 3399103. PMID 23155501.
- ^ Siqueira, J.P.Z.; Sutton, D.A.; Garcia, D.; Gené, J.; Thomson, P.; Wiederhold, N.; Guarro, J. (2016). "Species diversity of Aspergillus section Versicolores in clinical samples and antifungal susceptibility". Fungal Biology. 120 (11): 1458–1467. doi:10.1016/j.funbio.2016.02.006. PMID 27742099.
Further reading
- Jurjević Ž, Peterson SW, Solfrizzo M, Peraica M (2013). "Sterigmatocystin production by nine newly described Aspergillus species in section Versicolores grown on two different media". Mycotoxin Research. 29 (3): 141–5. doi:10.1007/s12550-013-0160-4. PMID 23417508. S2CID 255616298.
- Padarik ET, Oetari A, Fitri R, Susetyo-Salim T, Sjamsuridzal W (2016). "Diversity of fungi from old Dluwang manuscripts from Mertasinga, Cirebon". AIP Conference Proceedings. 1729 (1): 020068. doi:10.1063/1.4946971.